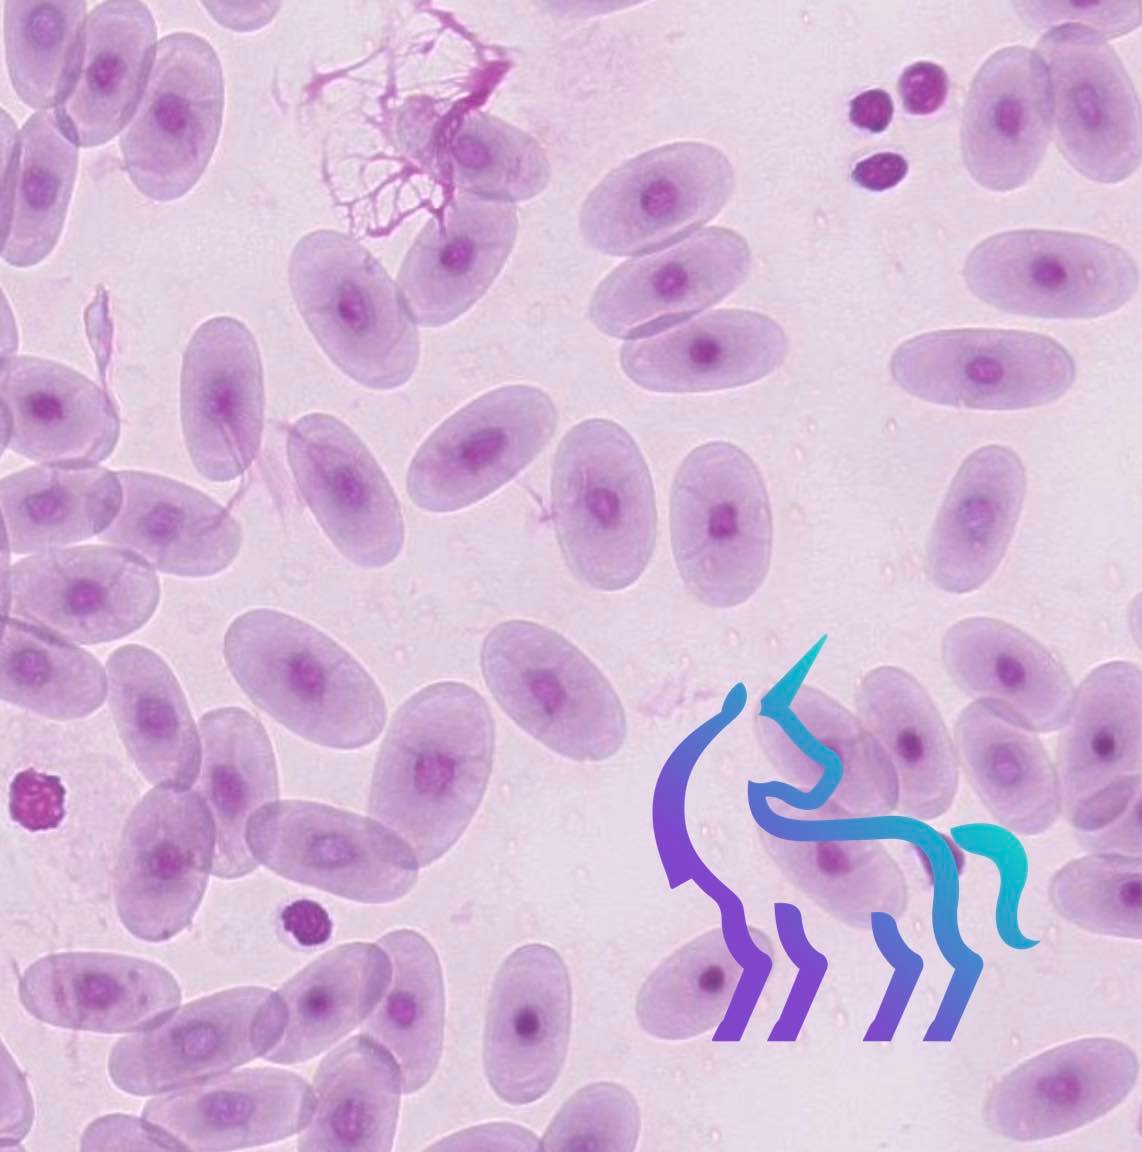
Frottis sanguin caïman

Le laboratoire d’analyses de Lingostière Clinique Vétérinaire
Disposer d’un laboratoire complet au sein de la clinique change concrètement la prise en charge des animaux. À Lingostière Clinique Vétérinaire, plus de 90 % des analyses sont réalisées sur place, avec des résultats disponibles en moins de 15 minutes dans la majority des situations. Cela permet d’agir vite, d’ajuster un traitement sans attendre et d’éviter des délais inutiles.
Un plateau technique de laboratoire complet sur site
Notre laboratoire s’appuie sur des équipements de dernière génération, reconnus pour leur fiabilité en médecine vétérinaire :
- Deux Catalyst IDEXX pour les analyses biochimiques.
- Un ProCyte Dx pour l’hématologie complète.
- Un SediVue Dx pour l’analyse automatisée des urines.
- Un IDEXX VetLab UA dédié aux examens urinaires.
- Un système de coagulation (Coag) pour l’évaluation rapide de l’hémostase.
- Un analyseur cellulaire IDEXX inVue Dx.
- La plateforme SNAP Pro pour les tests rapides (maladies infectieuses, endocrinologie).
- Un microscope de laboratoire pour l’examen direct des prélèvements.
- Le système Vetscan Imagyst pour la cytologie assistée par intelligence artificielle.
- L’automate KIMMUNO 1 pour les dosages immunologiques.
Examen microscopique direct : diagnostic immédiat
L’examen microscopique direct permet d’identifier sans délai des parasites externes, des levures ou des cristaux urinaires lors de la consultation. C’est un outil indispensable pour les pathologies cutanées des NAC comme la cheyletiellose.

Cytologie et masses : une réponse souvent dans l’heure
Grâce au Vetscan Imagyst, les cytologies de masses, nodules ou ponctions peuvent, dans de nombreux cas, être interprétées dans l’heure. Cela permet d’orienter rapidement la conduite à tenir.

Un laboratoire intégré au cœur de la prise en charge



